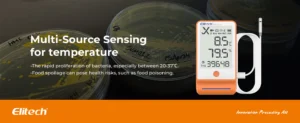

Designed for VACCINE

Full Upgrade

For Temperature

For Humidity

MKT Value

Bluetooth

Data Export

Shadow Data

Data Comparison

Why Buffered Probes?

LCD Interface

Device Details

Maximum Value










Elitech GSP-6Pro adalah Bluetooth Hygrometer Thermometer Data Logger yang mampu merekam suhu dan kelembapan hingga 100.000 titik data dengan fitur shadow data untuk keamanan penyimpanan.
Designed for VACCINE

Full Upgrade

For Temperature
For Humidity

MKT Value

Bluetooth

Data Export

Shadow Data

Data Comparison

Why Buffered Probes?

LCD Interface

Device Details

Maximum Value









